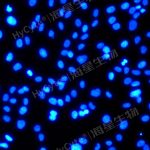
人脐静脉内皮细胞系HUVEC+完赔套装

广州泛思生物竭诚为您服务
发货周期:
干冰冻存管运输3天(5×10^5 cells/冻存管x1)
常温运温1-2周发货 (5×10^5 cells/cells/T25培养瓶)
(推荐T25瓶,复苏发货1-2周)
血管内皮细胞有助于维持血管平衡。血管内皮细胞产生并分泌凝血和纤维蛋白溶解系统的激活剂和抑制剂。此外,它们还介导血小板的粘附和聚集。内皮细胞还会释放调节细胞增殖和控制血管壁张力的分子。人脐静脉内皮细胞(HUVEC)是体外研究内皮细胞过程最常用的细胞类型。
海星生物提供的脐静脉内皮细胞系(HUVEC细胞系)取自自然分娩、健康的新生儿脐带组织经SV40T和hTERT转化,具有良好的传代能力及性状表现。
细胞名称:人脐静脉内皮细胞系(HUVEC细胞系)(经免疫荧光检测及血管形成能力验证)
人脐静脉内皮细胞系(HUVEC细胞系)为有限细胞系,使用海星配套完培,按照1:2传代,收货后承诺能再传5代。
细胞简称:HUVEC
产品货号:TCH-C406
种属来源:人
组织来源:脐带组织
疾病特征:—
细胞形态:内皮细胞样
生长特性:贴壁生长
培养体系:内皮细胞培养基础培养基+5% FBS+内皮细胞培养添加剂+1% P/S
消化时间:胰蛋白酶-EDTA消化液(0.25%)含酚红(胰酶)在37℃消化1-2min。
注:不同品牌胰酶不同细胞密度消化时间略有区别,以大部分细胞变圆脱落为准。
配套培养基货号:TCH-G406
传代比例:1:2,每2-3天换液一次
传代周期:48-72 h
培养条件:气相:95%空气+5%CO2,温度:37℃
冻存条件:60%基础培养基+30%FBS+10%DMSO,液氮储存
质量检测:细菌、真菌、支原体检测均为阴性
人脐静脉内皮细胞系(HUVEC细胞系) 传代图片:

人脐静脉内皮细胞系(HUVEC细胞系) 免疫荧光鉴定:

人脐静脉内皮细胞系(HUVEC细胞系) 血管形成能力验证:

人脐静脉内皮细胞系(HUVEC细胞系) 成管荧光验证:

实验方法:
1. 将对数生长期的HUVEC细胞系进行无血清饥饿处理16-24h。
2. 从冰箱中提前取出基质胶放入4 ℃的冰箱中过夜解冻,移液管或枪头需提前预冷,使用预冷的移液管或枪头混合基质胶至均匀状态。
3. 稀释基质胶,使用培养液将基质胶1:1混合均匀稀释到10 mg/mL,可根据实际情况进行调整。将完全解冻的基质胶放至在冰上,翻转几次以混合内容物后,48孔板中每孔加入150-200 μL。
4. 将加入了基质胶的48孔板转移到4 ℃冰箱中,在平整状态下孵育过夜,使基底膜形成凝胶并自流平,第二天使用前提前置于37 ℃使基质胶固化。
5. 对饥饿处理后达到80%融合的HUVEC细胞进行消化,离心,计数。
6. 将细胞重悬在各组别培养基中,使浓度为每毫升含2~3E5个细胞的单细胞悬液。48孔板中每孔加入含待测样本的200 μL细胞悬液(含4~6E4个细胞)。
7. 将孔板置于37 ℃,5%CO2,90%湿度条件的培养箱培养,并在不同时间点拍照观察,一般3-12小时可见血管网络形成,成管时间与细胞状态密切相关。
成血管实验注意要点:
1. 基质胶(货号:GUTK-R002-01)非常容易形成凝胶状态,在解冻过程中全程放在4 ℃,(可提前一天放置在4 ℃冰箱解冻预冷,准备一个-20 ℃的冰盒,将基质胶放置在冰盒上),在48孔板移液过程中全程在冰上操作。因此移液枪头也需要提前放至4 ℃预冷,也可将需要预冷的材料放至-20 ℃急冻。
2. 在向孔板中铺胶时,小心且垂直地将液体移入孔中,避免基质胶液体中出现气泡。如果出现气泡,将孔板在4 ℃下以300×g离心10 min,确保离心机预冷至4 ℃。实验过程中的所有耗材均需要提前放置在4 ℃冰箱中预冷。
3. 在37 ℃凝胶期间不要摇晃平板,因为这将导致凝胶表面不均匀。
4. 凝胶形成后先观察凝胶的形成状态,常会出现类似沙丘的隆起和沟壑,这时需要静置更长的时间,确保凝胶表面是平整均匀的状态后再进行实验。
5. 在接种细胞时,细胞活率要大于95%才可用于实验并得到一个准确的结果。
6. 当将细胞添加到孔中时,要确保细胞混合均匀,因为细胞密度对管的形成有影响。在加入细胞时,不要接触凝胶的表面,并缓慢地加入细胞悬液,以免损伤凝胶材料。
7. 在实验的第一个小时,不要摇动平板或将其从细胞培养箱中取出。在显微镜下观察平板时,不要在细胞培养箱外保存超过一两分钟。
8. 如需对成管进行荧光染色,荧光孵育时注意孵育时间,时间过长可能导致细胞弥散。
人脐静脉内皮细胞系(HUVEC细胞系)培养注意事项
1. 人脐静脉内皮细胞系(HUVEC细胞系)的培养基:
① 细胞状态对培养基更换敏感,请使用海星配套完培(货号:TCH-G406),否则会影响细胞状态及传代能力。
② 人脐静脉内皮细胞系(HUVEC细胞系)完全培养基中会少量沉淀物属于正常现象,不影响使用,不建议过滤将其去除,将会影响培养基的有效成分。
2. 人脐静脉内皮细胞系(HUVEC细胞系)的传代能力:
① 该细胞为有限传代细胞系,使用海星配套完培,按照1:2传代,收货后承诺能再传5代。
② 细胞培养中会有少量黑色颗粒及死细胞碎片的产生,属正常现象,可通过换液去除即可,不影响细胞培养。
③ 该细胞为有限细胞系,建议收到后尽快进行实验,不建议进行冻存保种。
3. 人脐静脉内皮细胞系(HUVEC细胞系)的消化:
① 该细胞对胰酶敏感;胰蛋白酶-EDTA消化液(0.25%)含酚红(胰酶)(货号:GUTP-R002)在37 ℃消化1-2min。不同品牌胰酶不同细胞密度消化时间略有区别,以80%细胞变圆脱落为准,如果消化全部脱离容易出现消化过度,影响细胞状态。
人脐静脉内皮细胞系(HUVEC细胞系)参考传代密度及消化程度:

② 该细胞传代后第二天会出现少量漂浮细胞,属于正常现象,换液即可去除,不影响细胞培养。
HUVEC 已发表过的文章:
IF=9.8 Gao R, Jiang Z, Wu X, et al. Metabolic regulation of tumor cells exposed to different oxygenated polycyclic aromatic hydrocarbons[J]. Science of The Total Environment, 2024, 907: 167833.
IF=8.1 Wang Z, Zhao P, Tian K, et al. TMEM9 promotes lung adenocarcinoma progression via activating the MEK/ERK/STAT3 pathway to induce VEGF expression[J]. Cell Death & Disease, 2024, 15(4): 295.
IF=5.9 Liu Q, Xie J, Zhou R, et al. A matrix metalloproteinase-responsive hydrogel system controls angiogenic peptide release for repair of cerebral ischemia/reperfusion injury[J]. Neural Regeneration Research, 2025, 20(2): 503-517.
IF=3.8 Shan Y, Xia Z, An M, et al. Construction and application of H1R ligand screening materials based on SMA stabilization and His-tag covalent immobilization of membrane proteins[J]. Journal of Chromatography A, 2024: 465057.
IF=3.6 Su J, Cheng J, Hu Y, et al. Transfer RNA-derived small RNAs and their potential roles in the therapeutic heterogeneity of sacubitril/valsartan in heart failure patients after acute myocardial infarction[J]. Frontiers in Cardiovascular Medicine, 2022, 9: 961700.
泛思生物